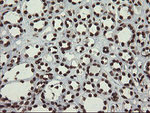
APEX1 Antibody in Immunohistochemistry (Paraffin) (IHC (P))

Search
OriGene
APEX1 Monoclonal Antibody (OTI6E10), TrueMAB™
{{$productOrderCtrl.translations['antibody.pdp.commerceCard.promotion.promotions']}}
{{$productOrderCtrl.translations['antibody.pdp.commerceCard.promotion.viewpromo']}}
{{$productOrderCtrl.translations['antibody.pdp.commerceCard.promotion.promocode']}}: {{promo.promoCode}} {{promo.promoTitle}} {{promo.promoDescription}}. {{$productOrderCtrl.translations['antibody.pdp.commerceCard.promotion.learnmore']}}
产品信息
CF800334
种属反应
宿主/亚型
分类
类型
克隆号
抗原
偶联物
形式
浓度
规格
纯化类型
保存液
内含物
保存条件
运输条件
产品详细信息
For reconstitution, we recommend adding 100 µL distilled water to a final antibody concentration of about 1 mg/mL. To use this carrier-free antibody for conjugation experiments, we strongly recommend performing another round of desalting. (Zeba Spin Desalting Columns, 7KMWCO, 0.5 mL, Product # 89882)
靶标信息
Mammalian apurinic/apyrimidinic endonuclease (APE/ref-1) is a multifunctional, bipartite enzyme that plays an important role in numerous, cellular functions. APE is responsible for repairing abasic sites in DNA and in regulating the redox state of other proteins that play roles in oxidative signaling, transcription factor regulation (Fos, Jun, NF-kB, Myb, HIF-1 alpha, CREB, Pax), cell cycle control (p53), and apoptosis. The most common form of DNA damage is the creation of abasic sites which are brought about through spontaneous loss or oxidative DNA damage, through chemically initiated hydrolysis (chemotherapy), ionizing radiation, UV irradiation, oxidizing agents, and removal of modified bases by DNA glycosylases. APE is differentially expressed during development and in different tissues. This protein has diverse subcellular localization patterns which support the possibility of its interaction with numerous, other cellular proteins in addition to DNA repair within the nucleus. Regulation of APE by phosphorylation is mediated, at least in part, by casein kinase II. Increases in APE message and protein levels are observed upon the reintroduction of oxygen to hypoxic cells, and in some malignant tissue relative to normal tissue. Decreases in APE expression have been associated with the induction of cellular apoptosis.
仅用于科研。不用于诊断过程。未经明确授权不得转售。
篇参考文献 (0)
生物信息学
蛋白别名: AP endonuclease 1; AP endonuclease class I; AP lyase; APEN; APEX nuclease; APEX nuclease (multifunctional DNA repair enzyme) 1; Apurinic-apyrimidinic endonuclease 1; apurinic/a; Apurinic/apy; apurinic/apyrimidinic (abasic) endonuclease; deoxyribonuclease (apurinic or apyrimidinic); DNA repair nuclease/redox regulator APEX1; DNA-(apurinic or apyrimidinic site) endonuclease; DNA-(apurinic or apyrimidinic site) lyase; HAP1; protein REF-1; redox factor; redox factor 1; Redox factor-1; REF-1; unnamed protein product
基因别名: APE; APE1; APEN; APEX; APEX1; APX; HAP1; REF1
UniProt ID: (Human) P27695
Entrez Gene ID: (Human) 328